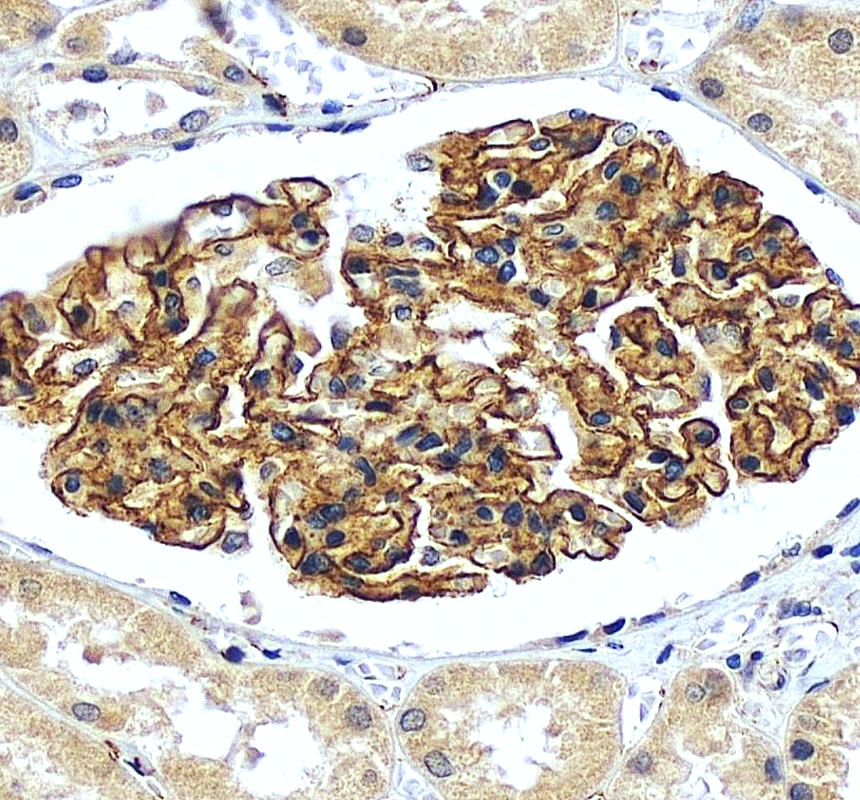

| Western blot (WB): | 1:500-2000 |
| Immunohistochemistry (IHC): | 1:50-400 |
| (Boiling the paraffin sections in 10mM citrate buffer,pH6.0,or PH8.0 EDTA repair liquid for 20 mins is required for the staining of formalin/paraffin sections.) Optimal working dilutions must be determined by end user. | |

Western blot analysis of Nephrin/NPHS1 using anti-Nephrin/NPHS1 antibody (A01991). The sample well of each lane was loaded with 30 ug of sample under reducing conditions.
Lane 1: rat kidney tissue lysates,
Lane 2: mouse kidney tissue lysates.
After electrophoresis, proteins were transferred to a membrane. Then the membrane was incubated with rabbit anti-Nephrin/NPHS1 antigen affinity purified polyclonal antibody (A01991) at a dilution of 1:1000 and probed with a goat anti-rabbit IgG-HRP secondary antibody (Catalog # BA1054). The signal is developed using ECL Plus Western Blotting Substrate (Catalog # AR1197). A specific band was detected for Nephrin/NPHS1 at approximately 185 kDa. The expected band size for Nephrin/NPHS1 is at 135 kDa.

IHC analysis of Nephrin/NPHS1 using anti-Nephrin/NPHS1 antibody (A01991).
Nephrin/NPHS1 was detected in a paraffin-embedded section of mouse kidney tissue. Biotinylated goat anti-rabbit IgG was used as secondary antibody. The tissue section was incubated with rabbit anti-Nephrin/NPHS1 Antibody (A01991) at a dilution of 1:200 and developed using Strepavidin-Biotin-Complex (SABC) (Catalog # SA1022) with DAB (Catalog # AR1027) as the chromogen.

IHC analysis of Nephrin/NPHS1 using anti-Nephrin/NPHS1 antibody (A01991).
Nephrin/NPHS1 was detected in a paraffin-embedded section of rat kidney tissue. Biotinylated goat anti-rabbit IgG was used as secondary antibody. The tissue section was incubated with rabbit anti-Nephrin/NPHS1 Antibody (A01991) at a dilution of 1:200 and developed using Strepavidin-Biotin-Complex (SABC) (Catalog # SA1022) with DAB (Catalog # AR1027) as the chromogen.

IHC analysis of Nephrin/NPHS1 using anti-Nephrin/NPHS1 antibody (A01991).
Nephrin/NPHS1 was detected in a paraffin-embedded section of human kidney tissue. The tissue section was incubated with rabbit anti-Nephrin/NPHS1 Antibody (A01991) at a dilution of 1:200 and developed using HRP Conjugated Rabbit IgG Super Vision Assay Kit (Catalog # SV0002) with DAB (Catalog # AR1027) as the chromogen.

Western blot analysis of Nephrin/NPHS1 using anti-Nephrin/NPHS1 antibody (A01991). The sample well of each lane was loaded with 30 ug of sample under reducing conditions.
Lane 1: rat kidney tissue lysates,
Lane 2: mouse kidney tissue lysates.
After electrophoresis, proteins were transferred to a membrane. Then the membrane was incubated with rabbit anti-Nephrin/NPHS1 antigen affinity purified polyclonal antibody (A01991) at a dilution of 1:1000 and probed with a goat anti-rabbit IgG-HRP secondary antibody (Catalog # BA1054). The signal is developed using ECL Plus Western Blotting Substrate (Catalog # AR1197). A specific band was detected for Nephrin/NPHS1 at approximately 185 kDa. The expected band size for Nephrin/NPHS1 is at 135 kDa.

IHC analysis of Nephrin/NPHS1 using anti-Nephrin/NPHS1 antibody (A01991).
Nephrin/NPHS1 was detected in a paraffin-embedded section of mouse kidney tissue. Biotinylated goat anti-rabbit IgG was used as secondary antibody. The tissue section was incubated with rabbit anti-Nephrin/NPHS1 Antibody (A01991) at a dilution of 1:200 and developed using Strepavidin-Biotin-Complex (SABC) (Catalog # SA1022) with DAB (Catalog # AR1027) as the chromogen.

IHC analysis of Nephrin/NPHS1 using anti-Nephrin/NPHS1 antibody (A01991).
Nephrin/NPHS1 was detected in a paraffin-embedded section of rat kidney tissue. Biotinylated goat anti-rabbit IgG was used as secondary antibody. The tissue section was incubated with rabbit anti-Nephrin/NPHS1 Antibody (A01991) at a dilution of 1:200 and developed using Strepavidin-Biotin-Complex (SABC) (Catalog # SA1022) with DAB (Catalog # AR1027) as the chromogen.

IHC analysis of Nephrin/NPHS1 using anti-Nephrin/NPHS1 antibody (A01991).
Nephrin/NPHS1 was detected in a paraffin-embedded section of human kidney tissue. The tissue section was incubated with rabbit anti-Nephrin/NPHS1 Antibody (A01991) at a dilution of 1:200 and developed using HRP Conjugated Rabbit IgG Super Vision Assay Kit (Catalog # SV0002) with DAB (Catalog # AR1027) as the chromogen.